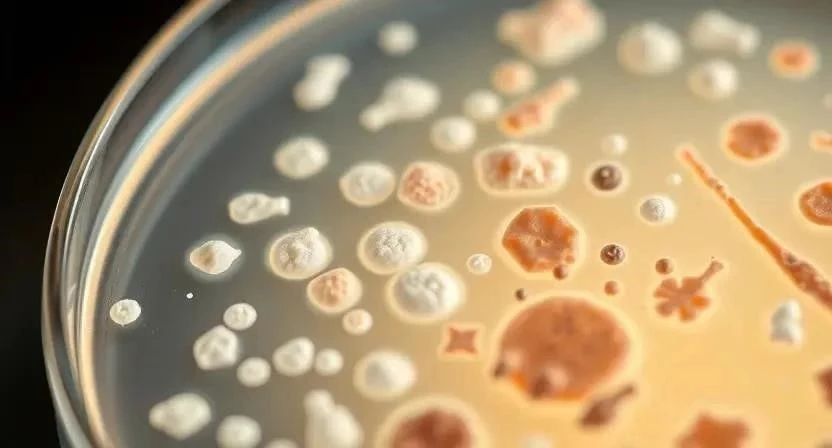

Задумывались ли вы, почему обычная простуда иногда перерастает в серьезное заболевание? Бактериальные инфекции дыхательной системы – это распространенная проблема, которая может затронуть каждого. По статистике, ежегодно миллионы людей во всем мире сталкиваются с этими инфекциями. Важно знать, как распознать симптомы и вовремя начать лечение. В этой статье мы подробно рассмотрим причины, симптомы, диагностику, лечение и профилактику бактериальных инфекций дыхательной системы.
Что такое бактериальные инфекции дыхательной системы
Бактериальные инфекции дыхательной системы – это заболевания, вызванные размножением бактерий в органах дыхания. Эти инфекции могут поражать верхние дыхательные пути (нос, горло, гортань) и нижние дыхательные пути (трахея, бронхи, легкие). Наиболее распространенными бактериями, вызывающими эти инфекции, являются Streptococcus pneumoniae, Haemophilus influenzae и Moraxella catarrhalis. Заражение происходит воздушно-капельным путем, при контакте с больным человеком или через загрязненные поверхности. Я помню, как однажды сам перенес бактериальный бронхит – это было неприятное ощущение, особенно тяжело было дышать.
Симптомы бактериальных инфекций
Симптомы бактериальных инфекций дыхательной системы могут варьироваться в зависимости от локализации инфекции и общего состояния организма. Общие симптомы включают кашель, повышенную температуру, слабость и усталость. При поражении верхних дыхательных путей могут наблюдаться боль в горле, насморк и головная боль. При поражении нижних дыхательных путей – одышка, боль в груди и затрудненное дыхание. Важно уметь различать симптомы, чтобы вовремя обратиться к врачу.
Таблица 1. Симптомы различных инфекций
| Инфекция | Основные симптомы |
|---|---|
| Пневмония | Высокая температура, кашель с мокротой, одышка, боль в груди |
| Бронхит | Кашель (сухой или с мокротой), одышка, слабость, температура |
| Фарингит | Боль в горле, покраснение горла, затрудненное глотание, температура |
| Ларингит | Охриплость голоса, боль в горле, сухой кашель |
| Ангина | Боль в горле, покраснение горла, гнойные пробки на миндалинах, температура |
| Бактериальный трахеит | Кашель, боль в груди, затрудненное дыхание, температура |
Диагностика
Диагностика бактериальных инфекций дыхательной системы включает сбор анамнеза, физикальный осмотр и лабораторные исследования. Анализ крови может выявить признаки воспаления и наличие бактерий. Анализ мокроты позволяет определить тип бактерий, вызвавших инфекцию. Рентген и КТ грудной клетки помогают оценить состояние легких и выявить признаки пневмонии или бронхита. Я всегда советую не заниматься самодиагностикой, а обратиться к квалифицированному врачу.
Таблица 2. Методы диагностики
| Метод | Описание | Преимущества | Недостатки |
|---|---|---|---|
| Анализ крови | Определение уровня лейкоцитов и других показателей воспаления | Быстрый и доступный | Не всегда позволяет точно определить тип бактерий |
| Анализ мокроты | Определение типа бактерий и их чувствительности к антибиотикам | Точный метод определения возбудителя | Требует времени для получения результатов |
| Рентген грудной клетки | Визуализация легких и выявление признаков пневмонии или бронхита | Быстрый и информативный | Облучение |
| КТ грудной клетки | Более детальное изображение легких | Высокая точность | Дорогостоящий и требует больше времени |
Лечение
Основным методом лечения бактериальных инфекций дыхательной системы является антибиотикотерапия. Выбор антибиотика зависит от типа бактерий, вызвавших инфекцию, и чувствительности к препарату. Важно строго соблюдать дозировку и длительность курса лечения, назначенные врачом. Помимо антибиотиков, рекомендуется симптоматическое лечение, включающее жаропонижающие, отхаркивающие и противовоспалительные препараты. Однажды я неправильно рассчитал дозировку антибиотика, и это привело к побочным эффектам. Будьте внимательны!
Таблица 3. Антибиотики и дозировки (примерные)
| Антибиотик | Дозировка (взрослым) | Длительность курса |
|---|---|---|
| Амоксициллин | 500 мг 3 раза в день | 7-10 дней |
| Азитромицин | 500 мг 1 раз в день в течение 3 дней | 3 дня |
| Цефтриаксон | 1-2 г 1 раз в день (внутримышечно или внутривенно) | 7-10 дней |
| Доксициклин | 100 мг 2 раза в день | 7-10 дней |
Профилактика
Профилактика бактериальных инфекций дыхательной системы включает укрепление иммунитета, вакцинацию, соблюдение правил гигиены и здоровый образ жизни. Важно регулярно мыть руки, избегать контакта с больными людьми, проветривать помещение и заниматься физическими упражнениями. Я стараюсь закаляться и правильно питаться, чтобы укрепить свой иммунитет.
- Регулярно мойте руки с мылом.
- Избегайте контакта с больными людьми.
- Проветривайте помещение.
- Занимайтесь физическими упражнениями.
- Правильно питайтесь.
- Соблюдайте режим сна и отдыха.
- Вакцинируйтесь от гриппа и пневмококковой инфекции.
Осложнения
При отсутствии своевременного лечения бактериальные инфекции дыхательной системы могут привести к серьезным осложнениям, таким как плеврит, абсцесс легкого и сепсис. Плеврит – это воспаление плевры, оболочки, окружающей легкие. Абсцесс легкого – это гнойное воспаление ткани легкого. Сепсис – это системная инфекция, которая может привести к полиорганной недостаточности. Поэтому важно не затягивать с лечением и обратиться к врачу при первых признаках заболевания.

Бактериальные инфекции у детей
Бактериальные инфекции дыхательной системы у детей протекают особенно тяжело. У детей младшего возраста иммунная система еще не полностью сформирована, поэтому они более восприимчивы к инфекциям. Симптомы у детей могут быть неспецифическими, что затрудняет диагностику. Важно своевременно обратиться к врачу и начать лечение. Я помню, как переживал, когда мой ребенок заболел бронхитом. Важно быть внимательным к своим детям.
FAQ
Вопрос: Какие антибиотики наиболее эффективны при бактериальных инфекциях дыхательной системы?
Ответ: Выбор антибиотика зависит от типа бактерий, вызвавших инфекцию, и чувствительности к препарату. Важно проконсультироваться с врачом.
Вопрос: Можно ли лечить бактериальные инфекции дыхательной системы народными средствами?
Ответ: Народные средства могут использоваться в качестве дополнения к основному лечению, но не заменяют его. Важно проконсультироваться с врачом.
Вопрос: Как предотвратить бактериальные инфекции дыхательной системы?
Ответ: Укрепляйте иммунитет, вакцинируйтесь, соблюдайте правила гигиены и ведите здоровый образ жизни.







